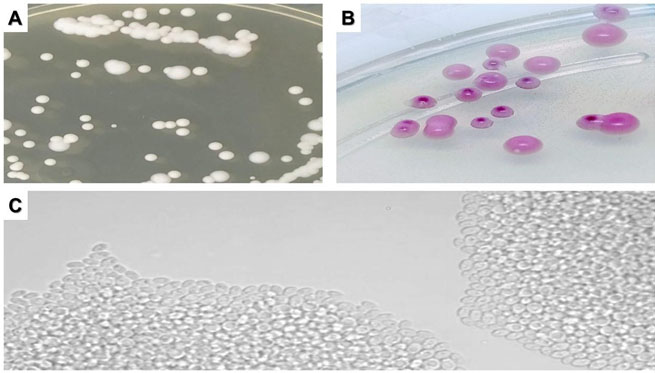
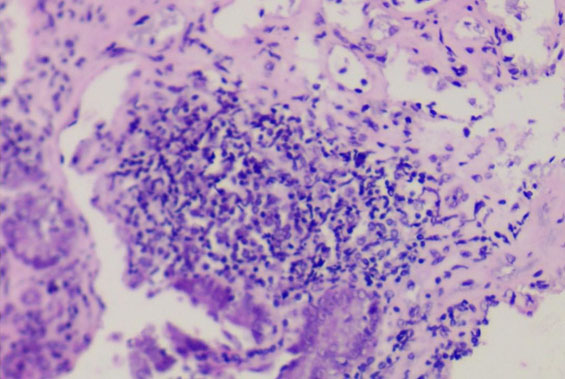

|
Case Report
The fungus Candida glabrata in intragastric balloon
1 MD, Medical Mycology Laboratory, Laboratory for Teaching and Research in Clinical Analysis, State University of Maringa, Brazil
2 Gastroenterologist Department of Diagnostic and Therapeutic Endoscopy, Mgastro Digestive Tract Medical Center, Maringá, Brazil
3 PhD, Coordinator of the Laboratory of General Pathology, State University of Maringá, Brazil
4 PhD, Medical Mycology Laboratory, Laboratory for Teaching and Research in Clinical Analysis, State University of Maringa, Brazil
Address correspondence to:
Terezinha Inez Estivalet Svidzinski
Av. Colombo, 5790, Block T20, Room 203, Maringá, Paraná,
Brazil
Message to Corresponding Author
Article ID: 101246Z01AP2021
Access full text article on other devices

Access PDF of article on other devices

How to cite this article
Prado A, Brito RO, Pereira ECA, Becker TCA, Negri M, Svidzinski TIE. The fungus Candida glabrata in intragastric balloon. Int J Case Rep Images 2021;12:101246Z01AP2021.ABSTRACT
Introduction: The relentless increase in the worldwide incidence of obesity has intensified the need for new treatments that are effective and safe. The intragastric balloon (IGB) is one such treatment that emerged. Fungal biofilms formed on medical devices and their relationship to infectious diseases is now well-established. However, studies regarding the microbial contamination suffered by this device are still incipient.
Case Report: We report here the first case of an IGB affected by a Candida glabrata biofilm, characterized by microbiological and scanning electron microscopy techniques. We verified yeasts, of the same species, in the mucosa of the duodenum, which was accompanied by lymphocytic infiltrate, as revealed through histopathological investigation.
Conclusion: Our findings highlight the importance of biofilm investigation on this type of device and to recognize the potential repercussions for the carrier since obese patients are immunocompromised and may undergo surgical interventions, thereby aggravating the risk of candidemia.
Keywords: Biofilm, Candida, Gastric balloon, Gastrointestinal endoscopy
Introduction
Obesity is a multifactorial chronic disease that challenges both medical teams and patients [1]. The search for new treatments to reduce obesity that are safe and effective led to the emergence of the intragastric balloon (IGB) in the mid-1980s [2]. The IGB is used to treat obesity by reversibly reducing gastric volume, which leads to early satiety. This device is indicated for individuals whose body mass index (BMI) is equal to or greater than 27 kg/m2 [3]. Even though the IGB is considered relatively safe, it has been reported to be a target for microbial contamination [4],[5],[6]. Microorganisms are known to have the ability to form biofilms, which are highly organized microbial communities immersed in an extrapolymeric matrix that confer resistance to physicochemical changes in the environment and the host immune response [7]. Numerous studies have evaluated the susceptibility of biomaterials to biofilm formation, especially those with a silicone composition, such as the IGB [8],[9]. Although most cases of fungal involvement of the device are asymptomatic, there are studies that relate the formation of fungal biofilms to hyperinflation [10]. This is a spontaneous increase in the volume of the device, which results in a difficulty in explantation [11]. The number of studies focusing this problem is still low. It makes difficult to elucidate some points of the involvement of IGB and the formation of microbial biofilms, such as the etiological agents, the origin of these microorganisms, as well as the consequences for patients with IGB affected by biofilms. Here, we report a case of an IGB contaminated by the fungus C. glabrata organized as a typical mature biofilm.
This study was approved by the Ethics Committee on Research involving Humans at the State University of Maringá (UEM), under number 3.266.181.
Case Report
A 42-year-old female, normoglycemic, weighing 91.9 kg, body mass index (BMI) of 33.4 kg/m2, grade I obesity, sedentary, chocoholic, non-smoker, and non-drinker, sought a private clinic for endoscopic bariatric treatment. After clinical and endoscopic evaluations, an adjustable IGB was indicated. This model was chosen because of the ability to perform volumetric adjustment during treatment and longer dwell time. The implantation of the device was performed on May 2, 2019, with 550 mL of initial volume containing sterile saline solution and methylene blue dye, the procedure succeeded uneventfully.
In the fourth month, a gastrointestinal endoscopy (GE) was performed in order to check the condition of the device. On this occasion, the presence of masses strongly adhered to the external surface of the device was identified, which were suggestive of microbial biofilm (Figure 1). In addition, it was observed that the tail of the device, used for volumetric adjustments, was entering the pylorus.
In the eighth month, the patient started to present pain in the right hypochondrium, as well as nausea and gastric distress, and underwent a new endoscopy. No evidence of gastric lesions was found, and biochemical and ultrasonography exams were performed, both without alterations. In the following months, analgesic medications were administered, however, complete analgesia was not achieved.
In the 11th month the patient developed iron deficiency anemia and received specific intravenous treatment. She also reported exacerbated gastric fullness, stomach pain, and emesis, so the protocol for explantation was initiated, which was performed 12 months after the implantation. The treatment was successful in terms of weight loss; the patient reached anthropometric levels of 66 kg and a BMI of 24.2 kg/m², with a 28% reduction in body mass.
After removal, the device was immediately sent to the Laboratory for Teaching and Research in Clinical Analysis (LEPAC) for mycological investigation. All regions of the device that macroscopically exhibited masses strongly adhered to its surface, i.e., body (Figure 2B), seam (Figure 2C), and tail (Figure 2D) were sampled by swab and cultured on Sabouraud Dextrose Agar (SDA), and the cultures were incubated at 35 °C for 48 h. Biopsy fragments from the duodenum (region proximal and distal to the stomach) were ground and cultured following the same protocol. Samples were also taken from the patient's tongue with a cytological brush, cultured in Sabouraud Dextrose Broth, and incubated at 35 °C for 48 h, then subcultured in SDA under the same conditions. All yeast-like colonies were identified by classical methods [12].
Culture of tongue samples were negative, but in all cultures of the tested segments of the IGB and the two duodenal regions C. glabrata was isolated (Figure 3).
In addition, fragments of the IGB containing the masses of microbial growth suggestive of biofilms were fixed in 0.1 M sodium cacodylate + 2.5% glutaraldehyde solution for scanning electron microscopy (SEM). Scanning electron microscopy micrographs showed ultrastructures typical of biofilms, confirming that the strongly adhered masses were fungal biofilms (Figure 4).
To evaluate a supposed reaction in the duodenal mucosa, biopsies of the proximal and distal regions were sent for histopathological analysis by H&E. In this analysis no signs of necrosis or granulation were observed, on the contrary, the tissue structure was preserved with the presence of a mild lymphocytic infiltrate (Figure 5).
After the explantation of the device, the patient had an improvement in her hypochondrial pain. So far, the patient remains with controlled obesity, maintaining a normotrophic BMI.
Discussion
Microbial colonization on the IGB was first recorded by Coskun and Bozkurt (2009) [5]. However, the laboratory methodology employed in that study was not directed at identifying the fungi, thus it was not defined which microorganisms were involved. Later, Kotzampassi (2013) [6] described a colonization by Candida albicans in a non-adjustable IGB. These authors reported a change in the topography of the device, which began to exhibit strongly adhered masses with a greenish, conical appearance on its surface [6]. Subsequently, Simsek (2014) [4] reported the presence of brownish plaques on air-filled and explanted IGBs from patients with different degrees of obesity and treatment time, and C. albicans was identified from these plaques. However, all three studies reported only fungal colonization, without reporting whether there was presence of microbial biofilm.
Here, we present and characterize, for the first time, a monomicrobial biofilm formed by the yeast-like fungus C. glabrata on an adjustable IGB. Our findings by SEM are in agreement with Timmermans et al. (2018) [13], who described a dense network of fungal cells embedded in an extrapolymeric matrix. This organization has been found to be responsible for tolerance to antifungal drugs and resistance to host immune mechanisms [14].
Candida albicans, reported in previous studies of IGBs [4],[6], is known to be a fungus with great ability to form biofilms on various biomaterials [15],[16]. Although this ability has already been well-described for C. glabrata [13], this species had not, until now, been reported to be found on an IGB. Interestingly, the macroscopic appearance of the masses found in the current study was similar to previous reports [4],[6]. Biofilms formed by both these species on medical devices have been associated with infectious processes, especially in immunocompromised patients [17].
In the IGB of the present case, C. glabrata was the species found forming the biofilm in all investigated segments of the balloon (Figure 2). The same species was also identified in cultures of the underlying organ, the duodenum, suggesting that these yeasts were not restricted to the surface of the device. However, it was not possible to clearly demonstrate if the origin of this yeast was from the intestinal microbiota itself, which ascended to contaminate the device. Alternatively, C. glabrata could have dispersed from the previously formed biofilm and then migrated to the duodenal mucosa. It is accepted that increased gastric pH favors intestinal fungal proliferation [18],[19]. A pH change occurs in all IGB carriers due to chronic use of proton pump inhibitors. Candida glabrata has been reported to be able to adapt and colonize all intestinal portions [20]. Some authors suggest that the fungal contamination of an IGB can occur during the implantation [5],[10]. In addition, the presence of fungus has previously been identified in the liquid that inflates the IGB [21]. Thus, the origin of fungal contamination of the IGB is still not clear, and we suggest the need for further studies on the possible relationship between biofilms on gastric devices and the intestinal microbiome.
Another point that drew our attention is the fact that the patient was not a smoker, which is a known risk factor for the formation of microbial biofilms [5]. She did, however, report a compulsion for chocolates, which could be associated with an overgrowth of microorganisms in her microbiota, as already pointed out in other studies that relate diet to the microbiota [22].
To our knowledge this is the first report of a fungal biofilm on an IGB, in a patient conveying some signs and symptoms (gastric pain, nausea, malaise) possibly related to the presence of the biofilm and the inflammation found in the duodenum (Figure 5). We suggest this explanation as the classic diagnostic means in gastroenterology were not able to evidence the etiology of the symptoms presented by the patient. The iron deficiency anemia can also be associated with the presence of C. glabrata in the biofilm. The consumption of iron from the environment is one of the virulence factors described for this species [23].
Despite little knowledge about the etiopathogenic potential of microorganisms involved in biofilms on IGBs, our findings allow us to hypothesize that these pose health risks, especially as a source of infectious agents [17]. Obese patients have an increased risk for infections of various types [24],[25], especially infections at abdominal anatomical sites. In addition, studies show that obese patients tend to have more severe repercussions in septic processes due to their pro-inflammatory profile [26]. Not infrequently, patients with IGB undergo subsequent bariatric surgical processes, thus accounting for the sum of predisposing factors to serious infections such as candidemia. It is noteworthy that after the explantation period, these patients are rarely followed-up, making it difficult to detect possible complications. According to Simsek (2014) [4], immunocompromised patients should be monitored after IGB explantation, especially those who have lesions on the gastric mucosa, considering the evidence that even infections that are initially asymptomatic can worsen. This scenario, compatible with the case presented here regarding the inflammatory process found in the mucosa, would justify a preventive treatment with antifungals [2],[4].
Conclusion
The presence of biofilms on an IGB should be a cause for concern since biofilms are a source of microorganisms and their relationship to disease etiology has already been established. The dispersion of these microorganisms in organ systems is closely related to infections that are difficult to treat and with high morbidity and mortality rates, especially when associated with other risk factors for infections, such as obesity, immunocompromised status, and possible future surgery. This risk seems more relevant when it comes to microorganisms that can adapt and survive in hostile environments, such as the stomach. Thus, the formation of fungal biofilms in IGBs, especially by highly pathogenic species such as C. glabrata, could be a decisive factor for post-explant follow-up, as well as being considered in the preoperative screening of individuals who are candidates for gastroplasty.
REFERENCES
1.
Ng M, Fleming T, Robinson M, et al. Global, regional, and national prevalence of overweight and obesity in children and adults during 1980–2013: A systematic analysis for the global burden of disease study 2013. Lancet 2014;384(9945):766–81. [CrossRef]
[Pubmed]

2.
Neto MG, Silva LB, Usuy EN Jr, Campos JM, editors. Intragastric Balloon for Weight Management: A Practical Guide. Cham: Springer International Publishing; 2020. [CrossRef]

3.
Schapiro M, Benjamin S, Blackburn G, et al. Obesity and the gastric balloon: A comprehensive workshop. Tarpon Springs, Florida, March 19–21, 1987. Gastrointest Endosc 1987;33(4):323–7. [CrossRef]
[Pubmed]

4.
Şimşek Z, Gürbüz OA, Çoban Ş. Fungal colonization of intragastric balloons. Endoscopy 2014;46 Suppl 1 UCTN:E642–3. [CrossRef]
[Pubmed]

5.
Coskun H, Bozkurt S. A case of asymptomatic fungal and bacterial colonization of an intragastric balloon. World J Gastroenterol 2009;15(45):5751–3. [CrossRef]
[Pubmed]

6.
Kotzampassi K, Vasilaki O, Stefanidou C, Grosomanidis V. Candida albicans colonization on an intragastric balloon. Asian J Endosc Surg 2013;6(3):214–6. [CrossRef]
[Pubmed]

7.
Paharik AE, Horswill AR. The staphylococcal biofilm: Adhesins, regulation, and host response. Microbiol Spectr 2016;4(2):10.1128/microbiolspec.VMBF-0022-2015. [CrossRef]
[Pubmed]

8.
Ramos RT, Leite GM, Martinez HV, Sibin KC, Germano A, Svidzinski T. Clinical and epidemiological characteristics of patients with central venous catheter colonized by yeasts. [Article in Portuguese]. Acta Med Port 2011;24 Suppl 2:257–62. [CrossRef]
[Pubmed]

9.
Gominet M, Compain F, Beloin C, Lebeaux D. Central venous catheters and biofilms: Where do we stand in 2017? APMIS 2017;125(4):365–75. [CrossRef]
[Pubmed]

10.
Barola S, Agnihotri A, Chiu AC, Kalloo AN, Kumbhari V. Spontaneous hyperinflation of an intragastric balloon 5 months after insertion. Am J Gastroenterol 2017;112(3):412. [CrossRef]
[Pubmed]

11.
Espinet-Coll E, Nebreda-Durán J; Turró-Arau R, Grupo Español de Endoscopia Bariátrica (GETTEMO). Difficult explant of intragastric balloon with severe fungal colonization: How do I do it? Response-commentary of the Spanish Bariatric Endoscopy Group. Gastroenterol Hepatol 2019;42(8):525–6. [CrossRef]
[Pubmed]

12.
13.
Timmermans B, De Las Peñas A, Castaño I, Van Dijck P. Adhesins in Candida glabrata. J Fungi (Basel) 2018;4(2):60. [CrossRef]
[Pubmed]

14.
Nett JE, Andes DR. Contributions of the biofilm matrix to Candida pathogenesis. J Fungi (Basel) 2020;6(1):21. [CrossRef]
[Pubmed]

15.
da Silveira LC, Charone S, Maia LC, de Araújo Soares RM, Portela MB. Biofilm formation by Candida species on silicone surfaces and latex pacifier nipples: An in vitro study. J Clin Pediatr Dent 2009;33(3):235–40. [CrossRef]
[Pubmed]

16.
Gulati M, Nobile CJ. Candida albicans biofilms: Development, regulation, and molecular mechanisms. Microbes Infect 2016;18(5):310–21. [CrossRef]
[Pubmed]

17.
Tsui C, Kong EF, Jabra-Rizk MA. Pathogenesis of Candida albicans biofilm. Pathog Dis 2016;74(4):ftw018. [CrossRef]
[Pubmed]

18.
Vesper B, Jawdi A, Altman KW, Haines GK 3rd, Tao L, Radosevich JA. The effect of proton pump inhibitors on the human microbiota. Curr Drug Metab 2009;10(1):84–9. [CrossRef]
[Pubmed]

19.
Jacobs C, Coss Adame E, Attaluri A, Valestin J, Rao SSC. Dysmotility and proton pump inhibitor use are independent risk factors for small intestinal bacterial and/or fungal overgrowth. Aliment Pharmacol Ther 2013;37(11):1103–11. [CrossRef]
[Pubmed]

20.
Charlet R, Pruvost Y, Tumba G, et al. Remodeling of the Candida glabrata cell wall in the gastrointestinal tract affects the gut microbiota and the immune response. Sci Rep 2018;8(1):3316. [CrossRef]
[Pubmed]

21.
Lopez-Nava G, Asokkumar R, Bautista I, Negi A. Spontaneous hyperinflation of intragastric balloon: What caused it? Endoscopy 2020;52(5):411–2. [CrossRef]
[Pubmed]

22.
Muñoz-Garach A, Diaz-Perdigones C, Tinahones FJ. Gut microbiota and type 2 diabetes mellitus. Endocrinol Nutr 2016;63(10):560–8. [CrossRef]
[Pubmed]

23.
Giolo MP, Svidzinski TIE. Fisiopatogenia, epidemiologia e diagnóstico laboratorial da candidemia. J Bras Patol Med Lab 2010;46(3):225–34. [CrossRef]

24.
Roujeau JC, Sigurgeirsson B, Korting HC, Kerl H, Paul C. Chronic dermatomycoses of the foot as risk factors for acute bacterial cellulitis of the leg: A case-control study. Dermatology 2004;209(4):301–7.
[Pubmed]

25.
Dobner J, Kaser S. Body mass index and the risk of infection – from underweight to obesity. Clin Microbiol Infect 2018;24(1):24–8. [CrossRef]
[Pubmed]

26.
Petronilho F, Giustina AD, Nascimento DZ, et al. Obesity exacerbates sepsis-induced oxidative damage in organs. Inflammation 2016;39(6):2062–71. [CrossRef]
[Pubmed]

SUPPORTING INFORMATION
Author Contributions
Andressa Prado - Conception of the work, Design of the work, Acquisition of data, Analysis of data, Drafting the work, Revising the work critically for important intellectual content, Final approval of the version to be published, Agree to be accountable for all aspects of the work in ensuring that questions related to the accuracy or integrity of any part of the work are appropriately investigated and resolved.
Rubens de Oliveira Brito - Acquisition of data, Drafting the work, Final approval of the version to be published, Agree to be accountable for all aspects of the work in ensuring that questions related to the accuracy or integrity of any part of the work are appropriately investigated and resolved.
Elton da Cruz Alves Pereira - Acquisition of data, Analysis of data, Drafting the work, Final approval of the version to be published, Agree to be accountable for all aspects of the work in ensuring that questions related to the accuracy or integrity of any part of the work are appropriately investigated and resolved.
Tania Cristina Alexandrino Becker - Drafting the work, Final approval of the version to be published, Agree to be accountable for all aspects of the work in ensuring that questions related to the accuracy or integrity of any part of the work are appropriately investigated and resolved.
Melyssa Negri - Conception of the work, Design of the work, Analysis of data, Drafting the work, Revising the work critically for important intellectual content, Final approval of the version to be published, Agree to be accountable for all aspects of the work in ensuring that questions related to the accuracy or integrity of any part of the work are appropriately investigated and resolved.
Terezinha Inez Estivalet Svidzinski - Conception of the work, Design of the work, Acquisition of data, Analysis of data, Drafting the work, Revising the work critically for important intellectual content, Final approval of the version to be published, Agree to be accountable for all aspects of the work in ensuring that questions related to the accuracy or integrity of any part of the work are appropriately investigated and resolved.
Guarantor of SubmissionThe corresponding author is the guarantor of submission.
Source of SupportNone
Consent StatementWritten informed consent was obtained from the patient for publication of this article.
Data AvailabilityAll relevant data are within the paper and its Supporting Information files.
Conflict of InterestAuthors declare no conflict of interest.
Copyright© 2021 Andressa Prado et al. This article is distributed under the terms of Creative Commons Attribution License which permits unrestricted use, distribution and reproduction in any medium provided the original author(s) and original publisher are properly credited. Please see the copyright policy on the journal website for more information.